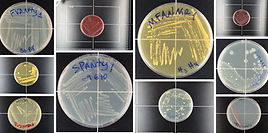
WhatsApp Image 2026-01-27 at 13.28.05.jpeg

Análise Laboratorial

Apoio à pesquisa científica no bioma da Mata Atlântica.
Aqui no Meliponário Atlante, em parceria com órgãos de pesquisa científica, são desenvolvidos estudos sobre as abelhas nativas indígenas, assim como da vegetação presente no bioma. Esse estudos são importantíssimos para que se entendam os comportamentos das abelhas frente a condições de clima e características botânicas dessa região, hoje considerada patrimônio mundial da UNESCO.
Estudo Microbiológico Global
O Meliponário Atlante faz parte de um estudo internacional sobre a microbiota intestinal das abelhas sem ferrão – Global bee microbiome profiling: Causes and consequences of host specificity in gut microbiomes.
O estudo tem uma abrangência ampla, em todas as regiões tropicais do planeta: América Latina, África, Sudeste Asiático e Austrália. E é conduzido no Laboratório de Microbiologia de Abelhas do Departamento de Microbiologia Fundamental da Universidade de Lausanne, na Suíça por um grupo de cientistas liderado pelos cientistas Carlos Gustavo Nunes da Silva e Philipp Engel.

Análise Laboratorial

Estudo de Bioma

Extensão Universitária
.jpeg)
GLOBAL BEE - Estudo Científico Universidade de Lausanne - Suíça
